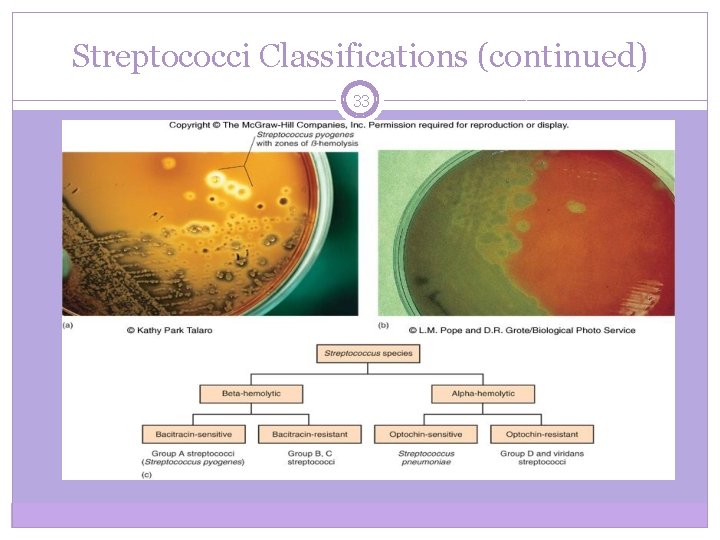
Streptococci Classifications (continued) 33
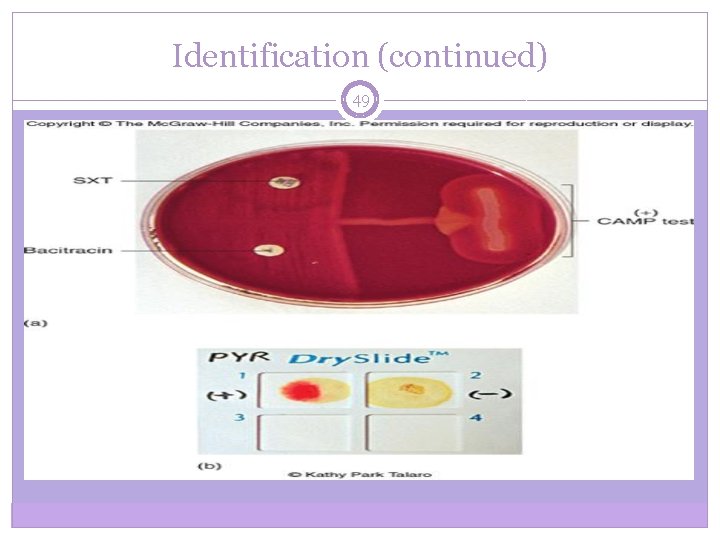
Identification (continued) 49

Gram Positive Stains and Bacterium 1 PRESENTED BY

Gram Positive Stains and Bacterium 1 PRESENTED BY: BRYANNA GRAY CONTACT INFORMATION: 240 -441 -9227 BRYANNA. GRAY@YAHOO. COM

4 Steps to Gram Staining 2 ① Pour on crystal violet stain (a blue dye) and wait 60 seconds. ② Wash off with water and flood with iodine solution. Wait 60 seconds. ③ Wash off with water and then "decolorize" with 95% alcohol. ④ Finally, counter-stain with safranin (a red dye). Wait 30 seconds and wash off with water.

The Result of Gram Staining 3

Gram Positive Stains: 4 u • Crystal violet gets trapped in the latticework u • Iodine acts as mordant (binding agent) u • Grams Alcohol shrinks latticework trapping stain & iodine u • Safranin (Red) - no space for it, hence purple stain outermost layer peptidoglycan layer Phospholipid Bilayer Cytoplasm

Gram Positive Cell Wall Properties: 5 Cell Wall – Peptidoglycan, NAG and NAM ① Peptidoglycan: a polymer that is composed of polysaccharide and peptide chains and is found especially in bacterial cell walls —called also mucopeptide, murein ② NAG(N-acetylglucosamine): the acetyl derivative of glucosamine; it is a component of structural glycosaminoglycans, glycolipids, and membrane glycoproteins ③ NAM: N-Acetylmuramic acid, or Mur. NAc, is the ether acetylglucosamine. It is part of a biopolymer in the bacterial cell wall, built from alternating units of N-acetylglucosamine (Glc. NAc) and Nacetylmuramic acid (Mur. NAc), cross-linked with oligopeptides at the lactic acid residue of Mur. NAc. This layered structure is called peptidoglycan.

Gram Positive Slide 6

POP QUIZ: (complete the chart) 7 Gram Positive Gram Negative Ex. Peptidoglycan Yes Ex. NAG Yes No NAM Lipopolysaccharide Cytoplasm Red Stain Purple Stain Enterococcus faecalis Corynebacterium diptheriae Neiserria gonorrhoeae S. pneumoniae Staphylococcus aureus Shigella Salmonella

Gram Positive Bacteria: 8 ① S. Aureus: Skin infection ② S. pneumoniae: pneumonia an infection that inflames the air sacs in one or both lungs. S. pneumoniae can also cause bacterial meningitis. Staphylococcus aureus Gram Positive Clostridium ① Clostridium: most notably S. Pneumoniae the causative agent of botulism. They are obligate anaerobes capable of producing endospores.

Gram Positive Infections 9 STAPHYLOCOCCUS GENUS

Characteristics of Staphylococci 10 �Common inhabitant of the skin and mucous membranes �Spherical cells arranged in irregular clusters �Gram-positive �Lack spores and flagella �May have capsules ` � 31 species �Facultative anaerobes �Staphylococcal Disease can range from localized to systemic

S. aureus Epidemiology and Pathology 11 �Present in most environments frequented by humans �Readily isolated from fomites �Carriage rate for healthy adults is 20 -60%. �Carriage is mostly in anterior nares, skin, nasopharynx, intestine. �Predisposition to infection include: poor hygiene and nutrition, tissue injury, preexisting primary infection, diabetes, immunodeficiency. �Increase in community acquired methicillin resistance MRSA

Local Staphylococcal Disease 12 Localized cutaneous infections–invade skin through wounds, follicles, or glands. �folliculitis–superficial inflammation of hair follicle; usually resolved with no complications but can progress �furuncle–boil; inflammation of hair follicle or sebaceous gland progresses into abscess or pustule �carbuncle–larger and deeper lesion created by aggregation and interconnection of a cluster of furuncles �impetigo –bubble-like swellings that can break and peel away; most common in newborns

Systemic Staphylococcal infection 13 �osteomyelitis–infection is established in the metaphysis; abscess forms �bacteremia -primary origin is bacteria from another infected site or medical devices; endocarditis possible

Staphylococcal Toxigenic Disease 14 Toxigenic disease �food intoxication–ingestion of heat stable enterotoxins; gastrointestinal distress �staphylococcal scalded skin syndrome–toxin induces bright red flush, blisters, then desquamation of the epidermis �toxic shock syndrome–toxemia leading to shock and organ failure

Staphylococcal Identification 15 �Frequently isolated from pus, tissue exudates, sputum, urine, and blood � • Cultivation, catalase, biochemical testing, coagulase

16

Clinical Concerns and Treatment 17 � 95% have penicillinase and are resistant to penicillin and ampicillin. � • MRSA –methicillin-resistant S. aureus–carry multiple resistance � • Abscesses have to be surgically perforated. � • Systemic infections require intensive lengthy therapy

Prevention of Staphylococcal Infection 18 � Universal precautions by healthcare providers to prevent nosocomial infections � • Hygiene and cleansing: � Wash your hands. Careful hand washing remains your best defense against germs. � � Scrub hands briskly for at least 15 seconds, then dry them with a disposable towel and use another towel to turn off the faucet. Carry a small bottle of hand sanitizer containing at least 62 percent alcohol for times when you don't have access to soap and water. Keep wounds covered. Keep cuts and abrasions clean and covered with sterile, dry bandages until they heal. The pus from infected sores may contain MRSA, and keeping wounds covered will help prevent the bacteria from spreading. Keep personal items personal. Avoid sharing personal items such as towels, sheets, razors, clothing and athletic equipment. MRSA spreads on contaminated objects as well as through direct contact. Shower after athletic games or practices. Shower immediately after each game or practice. Use soap and water. Don't share towels. Sanitize linens. If you have a cut or sore, wash towels and bed linens in a washing machine set to the hottest water setting (with added bleach, if possible) and dry them in a hot dryer. Wash gym and athletic clothes after each wearing.

Staphylococcus infections of Interest 19 �Of significance to humans are various strains of the species S. aureus and S. epidermidis.

Significance to Humans S. aureus 20 Staphylococcus aureus Strains of S. aureus are major agents of wound infections, boil, and other human skin infections and are one of the most common causes of food poisoning. S. aureus also causes meningitis, pneumonia, urinary tract infections, and infection of the breast in women or of the udder in domestic animals.

S. aureus 21 �Grows in large, round, opaque colonies � • Optimum temperature of 37 C � • Facultative anaerobe � • Withstands high salt, extremes in p. H, and high temperatures � • Carried in nasopharynx and skin � • Produces many virulence factors

Virulence Factors of S. aureus 22 �Coagulase –coagulates plasma and blood; produced by 97% of human isolates; diagnostic �Hyaluronidase –digests connective tissue �Staphylokinase –digests blood clots �DNase –digests DNA �Lipases –digest oils; enhances colonization on skin �Penicillinase –inactivates penicillin

Virulence Factors of S. aureus (continued) 23 Toxins �Hemolysins(α, β, γ, δ) –lyse red blood cells �Leukocidin–lyses neutrophils and macrophages �Enterotoxin–induce gastrointestinal distress �Exfoliative toxin–separates the epidermis from the dermis �Toxic shock syndrome toxin(TSST) -induces fever, vomiting, shock, systemic organ damage

Methicillin-resistant Staphylococcus aureus (MRSA) 24 �Methicillin-resistant Staphylococcus aureus (MRSA) infection is caused by a type of staph bacteria that's become resistant to many of the antibiotics used to treat ordinary staph infections. �Most MRSA infections occur in people who've been in hospitals or other health care settings, such as nursing homes and dialysis centers. When it occurs in these settings, it's known as health care-associated MRSA (HAMRSA). HA-MRSA infections typically are associated with invasive procedures or devices, such as surgeries, intravenous tubing or artificial joints.

Methicillin-resistant Staphylococcus aureus (MRSA). . continued 25 �Another type of MRSA infection has occurred in the wider community — among healthy people. This form, community-associated MRSA (CA-MRSA), often begins as a painful skin boil. It's spread by skin -to-skin contact. At-risk populations include groups such as high school wrestlers, child care workers and people who live in crowded conditions.

Symptoms of MRSA 26 Staph skin infections, including MRSA, generally start as swollen, painful red bumps that might resemble pimples or spider bites. The affected area might be: �Warm to the touch �Full of pus or other drainage �Accompanied by a fever These can quickly turn into deep, painful abscesses that require surgical draining. Sometimes the bacteria remain confined to the skin. But they can also burrow deep into the body, causing potentially life-threatening infections in bones, joints, surgical wounds, the bloodstream, heart valves and lungs

MRSA Treatment 27 Drug Treatment: Vancomycin (Vancocin) Vancomycin cause two types of hypersensitivity reactions, the red man syndrome and anaphylaxis Non- Drug treatment: �Both health care-associated and communityassociated strains of MRSA still respond to certain antibiotics. In some cases, antibiotics may not be necessary. For example, doctors may drain a superficial abscess caused by MRSA rather than treat the infection with drugs

Red Man Syndrome 28

Gram Positive Infections 29 STREPTOCOCCUS GENUS

Streptococcus 30 �Streptococcus is a genus of coccus (spherical) gram- positive bacteria belonging to the phylum Firmicutes[3] and the order Lactobacillales (lactic acid bacteria). Cell division in this genus occurs along a single axis in these bacteria, thus they grow in chains or pairs, hence the name—from Greek στρεπτός streptos, meaning easily bent or twisted, like a chain (twisted chain). (Contrast this with staphylococci, which divide along multiple axes and generate grape-like clusters of cells. )

General Characteristic of Streptococci 31 �Gram-positive spherical/ovoid cocci arranged in long chains; commonly in pairs �Non-spore-forming, nonmotile �Can form capsules and slime layers �Facultative anaerobes �Do not form catalase, but have a peroxidase system �Most parasitic forms are fastidious and require enriched media. �Small, nonpigmented colonies �Sensitive to drying, heat and disinfectants � 25 species

Streptococci Classifications 32 �Lancefield classification system based on cell wall Ag – 17 groups (A, B, C, …. ) �Another classification system is based on hemolysis reactions. �b-hemolysis –A, B, C, G and some D strains �a–hemolysis –S. pneumoniae and others collectively called viridans
Streptococci Classifications (continued) 33

Human Streptococcal Pathogens 34 �S. pyogenes �S. agalactiae �Viridans streptococci �S. pneumoniae �Enterococcus faecalis

Streptococcus pyogenes 35 �Streptococcus pyogenes is a species of bacteria. Like most other streptococci, it is clinically important in human illness. It is an infrequent, but usually pathogenic, part of the skin flora. It is the sole species of Lancefield group A and is often called group A streptococcus (GAS), because it displays streptococcal group A antigen on its cell wall. Group A streptococcal infection cause illness, which typically produces small zones of beta-hemolysis, a complete destruction of red blood cells. (A zone size of 2– 3 mm is typical). It is thus also called group A (betahemolytic) streptococcus (GABHS).

Beta-Hemolytic S. pyogenes 36 � • Most serious streptococcal pathogen � • Strict parasite � • Inhabits throat, nasopharynx, occasionally skin

Virulence Factors of Beta-hemolytic S. Pyogenes 37 �Produces surface antigens: �C-carbohydrates–protect against lysozyme �Fimbriae-adherence �M-protein–contributes to resistance to phagocytosis �Hyaluronic acid capsule –provokes no immune response

38

Virulence Factors of β-hemolytic S. pyogenes 39 �Extracellular toxins: �streptolysins–hemolysins; streptolysin O (SLO) and streptolysin S (SLS) –both cause cell and tissue injury �pyogenic toxin (erythrogenic)–induces fever and typical red rash �superantigens–strong monocyte and lymphocyte stimulants; cause the release of tissue necrotic factor

Virulence Factors of β-hemolytic S. pyogenes 40 �Extracellular enzymes �streptokinase –digests fibrin clots �hyaluronidase –breaks down connective tissue �DNase –hydrolyzes DNA

β-hemolytic S. pyogenes Epidemiology and Pathogenesis 41 �Humans only reservoir �In apparent carriers �Transmission –contact, droplets, food, fomites �Portal of entry generally skin or pharynx �Children predominant group affected for cutaneous and throat infections �Systemic infections and progressive sequelae possible if untreated

Scope of Clinical Disease 42 Skin infections �Impetigo (pyoderma)–superficial lesions that break and form highly contagious crust; often occurs in epidemics in school children; also associated with insect bites, poor hygiene, and crowded living conditions �Erysipelas–pathogen enters through a break in the skin and eventually spreads to the dermis and subcutaneous tissues; can remain superficial or become systemic Throat infections �Streptococcal pharyngitis–strep throat

Scope of Clinical Disease (continued) 43 �Systemic infections �Scarlet fever–strain of S. pyogenes carrying a prophage that codes for pyrogenic toxin can lead to sequelae �Septicemia �Pneumonia �Streptococcal toxic shock syndrome

Long- Term Complications of Group A infections 44 � • Rheumatic fever–follows overt or subclinical pharyngitis in children; carditis with extensive valve damage possible, arthritis, chorea, fever � • Acute glomerulonephritis–nephritis, increased blood pressure, occasionally heart failure; can become chronic leading to kidney failure

Group B: Streptococcus agalactiae 45 �Regularly resides in human vagina, pharynx and large intestine �Can be transferred to infant during delivery and cause severe infection –most prevalent cause of neonatal pneumonia, sepsis, and meningitis – 15, 000 infections and 5, 000 deaths in US –Pregnant women should be screened and treated. �Wound and skin infections and endocarditis in debilitated people

Group D Enterococci and Groups C and G Streptococci 46 Group D: �Enterococcus faecalis, E. faecium, E. durans �normal colonists of human large intestine �cause opportunistic urinary, wound, and skin infections, particularly in debilitated persons Groups C and G: �common animal flora, frequently isolated from upper respiratory;

Identification 47 �Cultivation and diagnosis ensure proper treatment to prevent possible complications. �Rapid diagnostic tests based on monoclonal antibodies that react with C-carbohydrates �Culture using bacitracin disc test, CAMP test

Identification (continued) 48
Identification (continued) 49

Treatment and Prevention 50 Good News Bad News �Group A and B are �NO VACCINES treated with penicillin �Sensitivity testing needed for enterococci AVAILABLE !!!!

Can you guess? 51 �Which of the below infections has the largest and most complex group? A. S. pyogenes B. S. agalactiae C. Viridans streptococci D. S. pneumoniae E. Enterococcus faecalis

α-Hemolytic Streptococci: Viridans Group 52 Large complex group –Streptococcus mutans, S. oralis, S. salivarus, �S. sanguis, S. milleri, S. mitis �Most numerous and widespread residents of the gums and teeth, oral cavity and also found in nasopharynx, genital tract, skin �Not very invasive; dental or surgical procedures facilitate entrance

Viridans Group 53 �Bacteremia, meningitis, abdominal infection, tooth abscesses �Most serious infection –subacute endocarditis–blood -borne bacteria settle and grow on heart lining or valves �Persons with preexisting heart disease are at high risk. �Colonization of heart by forming biofilms

Can you guess? 54 �How do dentist interact with the Viridans group? A. Dentist help by removing infected teeth. B. Dentist help prevent cavities C. Dentist help remove plaque D. Both B and C E. Dentist do not interact with the Viridans group.

S. mutans 55 �Produce slime layers that adhere to teeth, basis for plaque. �Involved in dental caries �Persons with preexisting heart conditions should receive prophylactic antibiotics before surgery or dental procedures.

Streptococcus pneumoniae: The Pneumococcus 56 �Causes 60 -70% of all bacterial pneumonias �Small, lancet-shaped cells arranged in pairs and short chains �Culture requires blood or chocolate agar. �Growth improved by 5 -10% CO 2 �Lack catalase and peroxidases –cultures die in O 2 �Causes pneumonia and otitis media

Epidemiology and Pathophysiology 57 � 5 -50% of all people carry it as normal flora in the nasopharynx; infections are usually endogenous. �Very delicate, does not survive long outside of its habitat �Young children, elderly, immune compromised, those with other lung diseases or viral infections, persons living in close quarters are predisposed to pneumonia �Pneumonia occurs when cells are aspirated into the lungs of susceptible individuals. �Pneumococci multiply and induce an overwhelming inflammatory response. �Gains access to middle ear by way of eustachian tube

58

Cultivation and Diagnosis 59 � • Gram stain of specimen –presumptive identification � • α-hemolytic; optochin sensitivity � • Quellung test or capsular swelling reaction

Treatment and Prevention 60 �Traditionally treated with penicillin G or V �Increased drug resistance �Two vaccines available for high risk individuals: –- capsular antigen vaccine for older adults and other high risk individuals - effective 5 years – conjugate vaccine for children 2 to 23 months

Gram Negative 61 CLOSTRIDIUM GENUS

Clostridium 62 �Gram-positive, spore-forming rods � • Anaerobic and catalase negative � • 120 species � • Oval or spherical spores produced only under anaerobic conditions � • Synthesize organic acids, alcohols, and exotoxins � • Cause wound infections, tissue infections, and food intoxications

Tetanus (lockjaw) 63 �Clostridium tetani �Common resident of soil and GI tracts of animals �Causes tetanus or lockjaw, a neuromuscular disease �Most commonly among geriatric patients and IV drug abusers; neonates in developing countries

Tetanus (continued) 64 �A serious bacterial infection that causes painful muscle spasms and can lead to death. �Extremely rare �Fewer than 1, 000 US cases per year �Spreads by contact with a contaminated object or surface �Requires a medical diagnosis �Lab tests or imaging not required �Medium-term: resolves within months

Tetanus Pathology 65 �Spores of the bacteria that cause tetanus, Clostridium tetani, are found in soil, dust and animal feces. When they enter a deep flesh wound, spores grow into bacteria that can produce a powerful toxin, tetanospasmin, which impairs the nerves that control your muscles (motor neurons). The toxin cause muscle stiffness and spasms — the major signs of tetanus. �Tetanospasmin–neurotoxin causes paralysis by binding to motor nerve endings; blocking the release of neurotransmitter for muscular contraction inhibition; muscles contract uncontrollably. �You can't catch tetanus from a person who has it.

66

Treatment and Prevention 67 �Treatment aimed at deterring degree of toxemia and infection and maintaining homeostasis �Antitoxin therapy with human tetanus immune globulin; inactivates circulating toxin but does not counteract that which is already bound �Control infection with penicillin or tetracycline; and muscle relaxants �Vaccine available; booster needed every 10 years

Clostridial Food Poisoning 68 � • Clostridium botulinum –rare but severe intoxication usually from home canned food � • Clostridium perfringens–mild intestinal illness; second most common form of food poisoning worldwide

Botulism 69 �Foodborne botulism. The harmful bacteria thrive and produce the toxin in environments with little oxygen, such as in canned food. �Wound botulism. If these bacteria get into a cut, they can cause a dangerous infection that produces the toxin. �Infant botulism. This most common form of botulism begins after Clostridium botulinum bacterial spores grow in a baby's intestinal tract. It typically occurs between the ages of 2 months and 8 months.

Food Bourne botulism Symptoms 70 � Signs and symptoms of foodborne botulism typically begin between 12 and 36 hours after the toxin gets into your body. But, the start of symptoms can range from a few hours to several days, depending on the amount of toxin ingested. Signs and symptoms of foodborne botulism include: � Difficulty swallowing or speaking � Dry mouth � Facial weakness on both sides of the face � Blurred or double vision � Drooping eyelids � Trouble breathing � Nausea, vomiting and abdominal cramps � Paralysis

Wound botulism Symptoms 71 �Most people who develop wound botulism inject drugs several times a day, so it's difficult to know for sure how long it takes for signs and symptoms to develop after the toxin enters the body. Wound botulism signs and symptoms include: �Difficulty swallowing or speaking �Facial weakness on both sides of the face �Blurred or double vision �Drooping eyelids �Trouble breathing �Paralysis

Infant botulism 72 � If infant botulism is related to food, such as honey, problems generally begin within 18 to 36 hours after the toxin enters the baby's body. Signs and symptoms include: � Constipation (often the first sign) � Floppy movements due to muscle weakness and trouble controlling the head � Weak cry � Irritability � Drooling � Drooping eyelids � Tiredness � Difficulty sucking or feeding � Paralysis

Botulism Treatment and Prevention 73 �Determine presence of toxin in food, intestinal contents or feces �Administer antitoxin; cardiac and respiratory support �Infectious botulism treated with penicillin �Practice proper methods of preserving and handling canned foods; addition of preservatives.

Check Your Knowledge: 74 ① What does Vancomycin treat and what ② ③ ④ ⑤ hypersensitivity is associated with it? What s the pathology of all infections discussed? Can you differentiate the difference between gram negative and gram positive? What type of infection is S. Aureus and what is its treatment? What type of infection is MRSA and how is it acquired? u. ANY QUESTIONS FOR ME? !? !? !

References: 75 ① http: //www. ppdictionary. com/gnbac. htm ② ③ ④ ⑤ ⑥ Parija SC (Jan 1, 2009). Textbook of Microbiology & Immunology. India: Elsevier. ISBN 8131221636. Kulp A, Kuehn MJ (2010). "Biological functions and biogenesis of secreted bacterial outer membrane vesicles". Annu. Rev. Microbiol. 64: 163– 84. doi: 10. 1146/annurev. micro. 091208. 073413. PMC 3525469. PMID 20825345. http: //study. com/academy/lesson/bacterial-cell-walls-andthe-gram-stain-test. html Dr. Kulkarn “Antibiotics Lecture” September 18, 2015 Menilik Tadesse “Gram Positive Infections” August 13, 2013
- Slides: 75